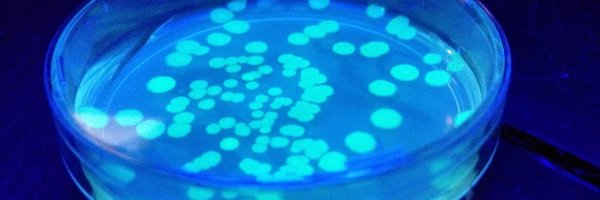
STEMReactor Profile Banner

STEM Reactor
@STEMReactor
Followers
188
Following
145
Media
52
Statuses
129
Biotechnology for Schools
Sydney, New South Wales
Joined May 2016
Really great to hear about the new STEM resources from @RAS_NSW Agriculture is such an important field to understand both economically and socially. It is an amazing way to experience authentic STEM experiences. #reinventheclassroom @ICTENSW
https://t.co/HxqMWKcFD1
0
0
0
CRISPR technology awarded the Nobel prize for chemistry:
abc.net.au
Emmanuelle Charpentier and Jennifer Doudna take home $1.5 million and a gold medal for developing a method for genome editing that could help cure inherited diseases in the future.
0
0
0
Last day of Term for 2019! 🙌 For making it to the end of the year! On to 2020! . #stemreactor #stem #stemed
#aussieed #aussiestem #AussieTeachers #Biotechnology #biologyteacher #scienceeducation #scienceed…
0
3
4
Celebrating a great year at the STANSW Christmas party! It was great to work with you this year, bigger and better things in 2020! . #stem #STEMed #aussieed #AussieTeachers #aussiestem #Biotechnology #biology…
instagram.com
0
0
0
Can't not share 😆 . . . .#STEM #stemeducation #STEMed #scienceteaching #scienceteaching #scienceed #aussieed #AussieTeachers #biotechnology #biologyteacher #biologyeducation
0
0
1
ASET conference 2019: thanks for inviting us to present at this year's science assistants conference. One session was In-Da-Pendant genes where we extracted or own DNA from cheek cells and made them into pendants to…
0
0
0
Went to this pitch night with @edugrowthaus and saw @neuranext talk about their incursions for schools teaching AI! So cool! #STEM #STEMed #scienceteaching #AussieEd #AussieSTEM #edtech #edtechaus
0
0
2
Gaden Fish Hatchery: went on an excellent tour of the Department of Primary Industries Fish Hatchery. A note for science teachers in NSW, they do sell fish and fertilised eggs your students can grow and study. DM me…
0
2
2
Today's session at #CONASTA68 was on cross-curricular teaching using forensic science. An awesome way to get students excited about STEM! We did blood splatter simulations, electrophoresis and talked about a bunch…
0
1
7
Ready for size exclusion chromatography. Home made retort stands courtesy of Bunnings! #STEMed #scienceed #AussieTeachers #STEM #biotechnology #biologyteacher
0
0
0
Another awesome weekend @GPN_Sydney. Learning how to program tic-tac-toe! #stem #STEMed #GirlsInSTEM #girlsintech
It took 8+ hours, but I figured out how to teach recursion and the minimax algorithm to kids for this weekend's @GPN_Sydney Tic-Tac-Toe Workshop! I had to play so many games of tic-tac-toe to find the perfect examples!! Want to know more? Come tutor https://t.co/qHxsmQHpZa
0
0
1
Another day another winner! Congratulations to Nicole, Turramurra high school! A week of Electrophoresis for you! . . #beeins2019 #STEMed #STEM #AussieTeachers #scienceed #scienceteaching
0
0
1
Fig wasps: these tiny male waits live their entire life inside the bulb of a fig. Only the females are winged and fly from fruit to fruit to find a mate, in the process pollinating the fig…
0
0
0
Congratulations to Ligia from St Benedict's for winning our raffle prize... Equipment rental for a week!!!! There's still another draw tomorrow so come say hi! . . #beeins2019 stansw…
0
0
0
Teachers always ask me how is best to store their DNA. I always say, as long as you don't freeze/thaw out to often it will last forever. We found proof today, we found an old DNA…
0
0
0
Pleasure discussing with @Bowenchris - the shadow treasure, how we use advanced manufacturing @NVIFlinders in @TonsleySA to make the best in class PhoneMicroscopes.
0
5
12
A huge welcome & hello to all our fellow educators joining us at the @austmus tonight! Director of Exhibitions, Engagement & Cultural Connection Russell Briggs give us a taste of what is to come in the next year; more focus on & facilities for education! 👏🙌
0
1
3
Love @JaneCaro's message. "You can't be what you can't see!!!" We need to celebrate the women Scientists and Mathematicians so that current female students can see the path~ Ada Lovelace, Florence Nightingale, (Jocelyn Bell-Burnell, Marie Curie, Annie Jump-Cannon) #scimathconf18
4
21
69